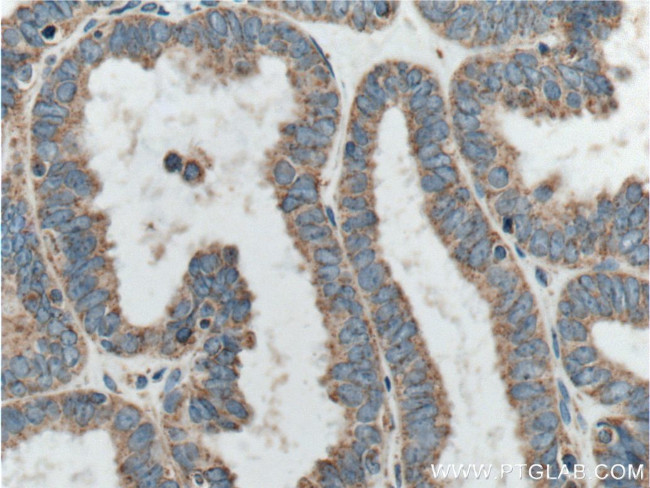
CORO2B Antibody in Immunohistochemistry (Paraffin) (IHC (P))

Search
Proteintech
CORO2B Polyclonal Antibody
{{$productOrderCtrl.translations['antibody.pdp.commerceCard.promotion.promotions']}}
{{$productOrderCtrl.translations['antibody.pdp.commerceCard.promotion.viewpromo']}}
{{$productOrderCtrl.translations['antibody.pdp.commerceCard.promotion.promocode']}}: {{promo.promoCode}} {{promo.promoTitle}} {{promo.promoDescription}}. {{$productOrderCtrl.translations['antibody.pdp.commerceCard.promotion.learnmore']}}
产品信息
13802-1-AP
种属反应
宿主/亚型
分类
类型
抗原
偶联物
形式
浓度
规格
纯化类型
保存液
内含物
保存条件
运输条件
产品详细信息
Immunogen sequence: MSWRPQYRS SKFRNVYGKV ANREHCFDGI PITKNVHDNH FCAVNTRFLA IVTESAGGGS FLVIPLEQTG RIEPNYPKVC GHQGNVLDIK WNPFIDNIIA SCSEDTSVRI WEIPEGGLKR NMTEALLELH GHSRRVGLVE WHPTTNNILF SAGYDYKVLI WNLDVGEPVK MIDCHTDVIL CMSFNTDGSL LTTTCKDKKL RVIEPRSGRV LQEANCKNHR VNRVVFLGNM KRLVTTGVSR WNTRQIALWD QEDLSMPLIE EEIDGLSGLL FPFYDADTHM LYLAGKGDGN IRYYEISTEK PYLSYLMEFR SPAPQKGLGV MPKHGLDVSA CE (1-331 aa encoded by BC026335)
靶标信息
May play a role in the reorganization of neuronal actin structure.
仅用于科研。不用于诊断过程。未经明确授权不得转售。
篇参考文献 (0)
生物信息学
蛋白别名: clipin C; Clipin-C; coronin, actin binding protein, 2B; Coronin-2B; Coronin-like protein C; E130012P22; Protein FC96; unnamed protein product
基因别名: CLIPINC; CORO2B; E130012P22Rik; KIAA0925
UniProt ID: (Human) Q9UQ03, (Mouse) Q8BH44
Entrez Gene ID: (Human) 10391, (Mouse) 235431, (Rat) 300768